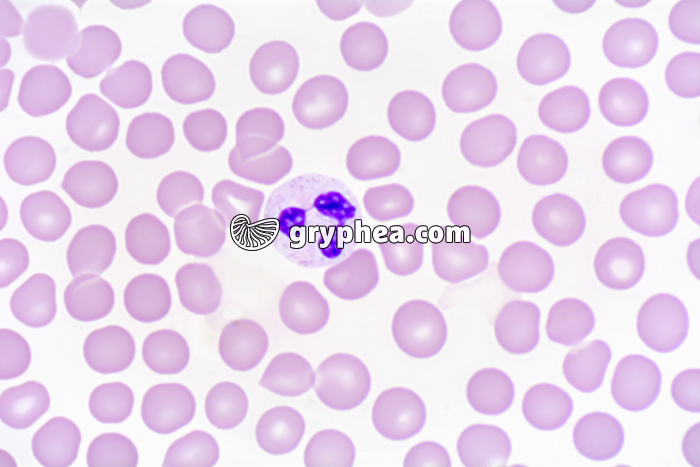
Sang humain, Granulocyte neutrohpile, frottis x400 - gryphea.org

Les photographies, infographies, vidéos, sons et textes publiés sur ce site ne sont pas totalement libres de droits. Vous pouvez les utiliser librement à titre personnel, dans la création de vos cours, compte-rendus, diaporamas, en respectant le watermark qui y est inclus, à la condition expresse d'avoir souscrit à un abonnement. Le contrat d’utilisation ne vous autorise cependant pas à diffuser ces documents ailleurs que dans le cadre strict de votre enseignement, et en aucun cas sur les réseaux sociaux. Merci de votre compréhension.
Pour accéder à tous les contenus de gryphea.org, aux photos haute définition et aux vidéos intégrales, profitez de nos offres d'abonnement :
Chez les Vertébrés, le sang est un liquide biologique vital qui circule dans un système clos, le système circulatoire (vaisseaux et capillaires sanguins), sous l’action d’un muscle creux à fonctionnement automatique, le coeur. Ce fluide rouge est composé en grande partie d’un liquide complexe, le plasma, de cellules sanguines très nombreuses et de très petite taille, les globules rouges, qui confèrent au sang sa couleur particulière, ainsi que de cellules à rôle immunitaire, les globules blancs.
Outre les cellules sanguines, le sang assure le transport des éléments nutritifs fournis par l’alimentation, libérés ou synthétisés par certains organes, les gaz respiratoires (O2 et CO2), les déchets métaboliques, ainsi que les molécules du système immunitaire et les molécules hormonales. Les éléments figurés du sang (cellules) sont formés en permanence au niveau de la moelle osseuse (hématopoïèse).
Chez les mammifères, les[...]
La suite du commentaire est réservée aux abonnés